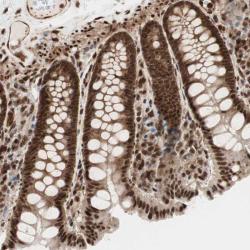

Antibody data
- Antibody Data
- Antigen structure
- References [10]
- Comments [0]
- Validations
- Immunohistochemistry [1]
Submit
Validation data
Reference
Comment
Report error
- Product number
- sc-1656 - Provider product page

- Provider
- Santa Cruz Biotechnology
- Proper citation
- Santa Cruz Biotechnology Cat#sc-1656, RRID:AB_2197067
- Product name
- Anti-STAT5B
- Antibody type
- Monoclonal
- Antigen
- Synthetic peptide
- Reactivity
- Human
- Host
- Mouse
Submitted references Role of ERalpha in the differential response of Stat5a loss in susceptibility to mammary preneoplasia and DMBA-induced carcinogenesis.
Oncoproteomic analysis reveals co-upregulation of RELA and STAT5 in carboplatin resistant ovarian carcinoma.
Uremia attenuates growth hormone-stimulated insulin-like growth factor-1 expression, a process worsened by inflammation
The 15(S)-hydroxyeicosatetraenoic acid-induced angiogenesis requires Janus kinase 2-signal transducer and activator of transcription-5B-dependent expression of interleukin-8.
Proteasomes can degrade a significant proportion of cellular proteins independent of ubiquitination.
Endotoxin-induced growth hormone resistance in skeletal muscle.
Human and simian immunodeficiency viruses deregulate early hematopoiesis through a Nef/PPARgamma/STAT5 signaling pathway in macaques.
JAK2, but not Src family kinases, is required for STAT, ERK, and Akt signaling in response to growth hormone in preadipocytes and hepatoma cells.
Suppression of activation of signal transducer and activator of transcription-5B signaling in the vessel wall reduces balloon injury-induced neointima formation.
Nuclear factor kappaB-dependent gene expression profiling of Hodgkin's disease tumor cells, pathogenetic significance, and link to constitutive signal transducer and activator of transcription 5a activity.
Miermont AM, Parrish AR, Furth PA
Carcinogenesis 2010 Jun;31(6):1124-31
Carcinogenesis 2010 Jun;31(6):1124-31
Oncoproteomic analysis reveals co-upregulation of RELA and STAT5 in carboplatin resistant ovarian carcinoma.
Jinawath N, Vasoontara C, Jinawath A, Fang X, Zhao K, Yap KL, Guo T, Lee CS, Wang W, Balgley BM, Davidson B, Wang TL, Shih IeM
PloS one 2010 Jun 18;5(6):e11198
PloS one 2010 Jun 18;5(6):e11198
Uremia attenuates growth hormone-stimulated insulin-like growth factor-1 expression, a process worsened by inflammation
Yu Chen, Jaclyn Biada, Sumita Sood, Ralph Rabkin
Kidney International 2010 Apr;78(1):89-95
Kidney International 2010 Apr;78(1):89-95
The 15(S)-hydroxyeicosatetraenoic acid-induced angiogenesis requires Janus kinase 2-signal transducer and activator of transcription-5B-dependent expression of interleukin-8.
Cheranov SY, Wang D, Kundumani-Sridharan V, Karpurapu M, Zhang Q, Chava KR, Rao GN
Blood 2009 Jun 4;113(23):6023-33
Blood 2009 Jun 4;113(23):6023-33
Proteasomes can degrade a significant proportion of cellular proteins independent of ubiquitination.
Baugh JM, Viktorova EG, Pilipenko EV
Journal of molecular biology 2009 Feb 27;386(3):814-27
Journal of molecular biology 2009 Feb 27;386(3):814-27
Endotoxin-induced growth hormone resistance in skeletal muscle.
Chen Y, Sood S, Krishnamurthy VM, Rotwein P, Rabkin R
Endocrinology 2009 Aug;150(8):3620-6
Endocrinology 2009 Aug;150(8):3620-6
Human and simian immunodeficiency viruses deregulate early hematopoiesis through a Nef/PPARgamma/STAT5 signaling pathway in macaques.
Prost S, Le Dantec M, Augé S, Le Grand R, Derdouch S, Auregan G, Déglon N, Relouzat F, Aubertin AM, Maillere B, Dusanter-Fourt I, Kirszenbaum M
The Journal of clinical investigation 2008 May;118(5):1765-75
The Journal of clinical investigation 2008 May;118(5):1765-75
JAK2, but not Src family kinases, is required for STAT, ERK, and Akt signaling in response to growth hormone in preadipocytes and hepatoma cells.
Jin H, Lanning NJ, Carter-Su C
Molecular endocrinology (Baltimore, Md.) 2008 Aug;22(8):1825-41
Molecular endocrinology (Baltimore, Md.) 2008 Aug;22(8):1825-41
Suppression of activation of signal transducer and activator of transcription-5B signaling in the vessel wall reduces balloon injury-induced neointima formation.
Kundumani-Sridharan V, Wang D, Karpurapu M, Liu Z, Zhang C, Dronadula N, Rao GN
The American journal of pathology 2007 Oct;171(4):1381-94
The American journal of pathology 2007 Oct;171(4):1381-94
Nuclear factor kappaB-dependent gene expression profiling of Hodgkin's disease tumor cells, pathogenetic significance, and link to constitutive signal transducer and activator of transcription 5a activity.
Hinz M, Lemke P, Anagnostopoulos I, Hacker C, Krappmann D, Mathas S, Dörken B, Zenke M, Stein H, Scheidereit C
The Journal of experimental medicine 2002 Sep 2;196(5):605-17
The Journal of experimental medicine 2002 Sep 2;196(5):605-17
No comments: Submit comment
Supportive validation
- Submitted by
- per
- Main image
- Experimental details
- Immunohistochemical staining of human colon shows strong cytoplasmic and nuclear positivity in glandular cells.
- Validation comment
- Staining pattern partly consistent with experimental and/or bioinformatic data.